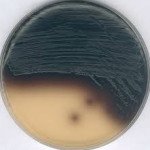
KANAMYCIN ESCULIN AZIDE AGAR FOR MICROBIOLOGY

GranuCult® plus Kanamycin esculin azide agar is a highly selective media for D-streptococci. Kanamycin and azide inhibit the accompanying bacterial flora. D-streptococci are, however, only slightly sensitive to these substances, so they grow normally and hydrolyze the glucoside esculin to give glucose and esculetin. Esculetin forms an olive-green to-black complex with iron (III) ions.
Appearance (clearness): clear
Appearance (colour): brown-bluish
pH-value (25 °C): 6.9 - 7.3
Recovery on test medium (Enterococcus faecalis ATCC 11700): ≥ 70 %
Recovery on test medium (Enterococcus hirae ATCC 8043 (WDCM 00089)): ≥ 70 %
Recovery on test medium (Enterococcus durans ATCC 6056): ≥ 70 %
Recovery on test medium (Staphylococcus aureus ATCC 6538-P (WDCM 00033)): no limit
Recovery on test medium (Bacillus cereus ATCC 11778 (WDCM 00001)): ≤ 0.01 %
Recovery on test medium (Escherichia coli ATCC 11775 (WDCM 00090)): ≤ 0.01 %
Colour change to olivegreen-black (Enterococcus faecalis ATCC 11700): +
Colour change to olivegreen-black (Enterococcus hirae ATCC 8043 (WDCM 00089)): +
Colour change to olivegreen-black (Enterococcus durans ATCC 6056): +
Colour change to olivegreen-black (Staphylococcus aureus ATCC 6538-P (WDCM 00033)): -
Colour change to olivegreen-black (Bacillus cereus ATCC 11778 (WDCM 00001)): -
Colour change to olivegreen-black (Escherichia coli ATCC 11775 (WDCM 00090)): -
Incubation: 48 hrs.; 35 °C; aerobic.